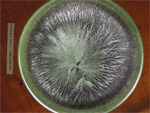

« Tout ce que la terre
nous apprend
nous guide dans
notre travail avec elle »
FD
Exemples d'études
Exemple 1 - Exemple 2Exemple 2 : Etude de terre + plantes accompagnatrices
Réalisée avec 2 cristallisations à 15 jours d'intervalle pour la terre et 3 cristallisations à 8 jours d'intervalle pour les plantes, cette étude donne la situation approfondie de la terre : personnalité, problèmes, potentialités de fertilité et propositions d'action.
Parcelle "La Pièce à Madame"(Vienne)
Etude de deux échantillons de terre :- un reçu le 10 mars 2012, prélevé à 60 cm de profondeur
- un reçu le 26 mars 2012, prélevé à 30 cm de profondeur (même zone que le précédent)
Etude de trois plantes "accompagnatrices" de cette terre, reçues le 26 mars 2012
- carotte sauvage, présente dans toute la parcelle
- chiendent rampant, plutôt présent dans la partie "grosse terre" où ont été pris les échantillons
- liseron des champs, présent en rond un peu partout
Le fait que cette étude porte sur deux échantillons prélevés à des profondeurs différentes a permis de mettre en évidence que les problèmes de cette terre étaient plus visibles et perceptibles à 60 cm de profondeur.
De même, l'étude de trois plantes "accompagnatrices" a montré que toutes les trois dénotent les mêmes difficultés de la terre mais aussi l'action très particulière de chacune d'elle dans cette parcelle précisément.
A titre d'information, le nombre d'images étudiées est généralement de :
- 4 à 6 pour un échantillon de terre (Jour 1 et Jour 15)
- 6 à 9 pour un échantillon de plante "accompagnatrice" (Jour 1, Jour 8 et Jour 15)
Pour l'exemple choisi, les images jointes concerneront le Jour 1 uniquement, afin de ne pas alourdir la présentation.
I- Etude des échantillons de terre
Impression générale :(...) L'étude va se faire simultanément sur les deux échantillons qui présentent les mêmes informations, bien qu'un peu plus marquées sur l'échantillon à 60 cm de profondeur.
Images principales : concentration à respectivement 0,66 g pour la terre à 30 cm et 0,60 g pour la terre à 60 cm (photos n° 1 et n° 4)
Complétées par des images à faible concentration 0,33 g, 0,17 g pour la terre à 30 cm (photos n° 2 et n° 3) et 0,20 g, 0,10 g pour la terre à 60 cm avec des concentrations faibles à très faibles de chlorure de cuivre (photos n° 5 et n° 6)
Cliquez sur les photos pour les agrandir
- Terre à 60 cm de profondeur
Jour 1 (14 mars 2012) - Terre à 60 cm de profondeur
Jour 1 (14 mars 2012) - Terre à 60 cm de profondeur
Jour 1 (14 mars 2012)
- Photo n°4
- Photo n°5
(image complémentaire) - Photo n°6 (image complémentaire)
Descriptif technique succinct :
Centre vers le bas
Vacuoles type fruit, parfois graine (en principe pour la terre, centre racine c'est-à-dire pas de vacuoles
Champ supérieur (zone autour du centre) : structure très resserrée avec faisceaux très peu ramifiés, texture extrêmement dense, ce qui donne lieu à une impression de feutrage (plus particulièrement à 30 cm) avec une importante superposition des aiguilles ce qui donne du relief++, de l'épaisseur++ (plus visible et plus significatif à 60 cm)
Champ médian (zone intermédiaire) : même phénomène que dans le champ supérieur sur une moitié gauche de ce champ à 60 cm et premier tiers haut avec prolongement sur une petite partie du 2ème tiers haut à 30 cm : les faisceaux se déploient avec un mouvement ondoyant , très ourlés et ouvragés (dentelés), puis les faisceaux présentent des aiguilles plus fines et rectilignes, les terminaisons sont amples très bien ramifiées
Rayonnement domine, plus particulièrement en champ supérieur
Déploiement cependant avec une certaine souplesse (plus visible à 60 cm)
Champ inférieur (zone périphérique) visiblement dense et serré bien que feutré
Cette terre est une terre mature, ancienne voire ancestrale, bien établie , "bien assise", bien ancrée, affirmée, expérimentée, sage.
Elle contient des forces de production, voire de reproduction (cela sera plus détaillé au troisième paragraphe).
Cette terre est d'une grande puissance, elle contient beaucoup de force, comme une vague de fond très lente qui vient d'une grande profondeur. Cette puissance est soutenue, lente, fluide, pleine et ronde. Cette terre a un rythme lent qui lui est propre. (...)
C'est une terre riche et généreuse (...).
C'est une terre magnifique, avec une consistance "charnue", abondante, malléable, onctueuse et souple. Il s'en dégage de la douceur, elle est bonne "comme du bon pain". (...)
Elle allie finesse et délicatesse à une rusticité et une rugosité, celle d'une bonne nourrice, simple, sans ambigüité. (...)
Il s'agit là de la personnalité propre à cette terre "La Pièce à Madame". Toutes ces particularités, ces qualités sont intrinsèques à cette terre, c'est-à-dire qu'elles font partie de sa nature profonde, qu'elles sont là même si, comme nous allons le voir, elles ne peuvent pas toujours pleinement s'exprimer.
2°/ Problèmes, difficultés :
Descriptif technique succinct :
Feutrage+ , extrêmement serré, rendant illisibles les aiguilles superposées, car gênées, contenues pour avancer, dans le champ supérieur et une partie du champ médian
Rétraction, en de nombreux endroits (surtout à 60 cm) des amas d'aiguilles "en paquet" font obstruction à la formation des ramifications et témoignent de la difficulté à se déployer, plus visible à 60 cm (photos n° 4, n° 33, n° 35)
Ralentissement++ de la formation des aiguilles et des ramifications
Elargissement zone périphérique et dépôt important de chlorure de cuivre en bordure, à 60 cm
Asymétrie : perturbation de l'équilibre fonctionnel
Striations moirées dans le dernier tiers du champ médian à 30 cm et deuxième moitié de ce même champ à 60 cm, ainsi que sur une partie de la zone périphérique = rétention hydrique dans cristal
Cercles concentriques++ en périphérie et amincissement passager des ramifications en zone intermédiaire (ces phénomènes sont plus visibles et plus marqués sur les images à faible concentration comme dans image multicentrée 12.72' J1 C0.2 0) (photo n°5)
Luminosité accrue dans les zones centrales
Structure rayonnante, aiguilles et ramifications plus rectilignes sur la dernière partie de la zone intermédiaire (côté droit)
Structure transverse : substrat vieilli, pourri ou tumeur végétale (facteur de dégénérescence cellulaire) dans la dernière partie de la zone intermédiaire - +++ en J15 (photos n° 31 et n° 32)
Dépôts+++ sur zone périphérique et terminaisons zone intermédiaire.
Premier problème : Rétraction qui signifie compaction sévère
C'est le problème le plus visible immédiatement sur les deux images. Toutes les forces sont principalement contenues dans la partie centrale. La terre est repliée sur elle-même, elle se recroqueville, se ratatine,(...). Elle est empêchée, s'étouffe, sa respiration est ralentie. Il y a là tous les signes d'une compaction qui s'est installée d'une manière progressive, sournoise, insidieuse. (...). Le phénomène est déjà ancien, l'élargissement de manière conséquente de la zone périphérique témoigne d'un affaiblissement, d'un épuisement. Comme la terre est pleine de ressources, elle arrive encore à fonctionner, bien qu'en étant perturbée comme en témoigne l'asymétrie visible sur les deux images.
Deuxième problème : la circulation hydrique
Ce problème est consécutif du premier, et une fois présent, il accentue la compaction et les dysfonctionnements du sol. La terre est trop humide en période froide (striations moirées) et par là elle a du mal à se réchauffer. Par contre en période sèche, elle se met à avoir une chaleur excessive (la forte luminosité centrale témoigne de ce "feu").
Il en découle une alimentation en eau qui se fait par "à coups" comme cela est bien visible sur les images des plantes accompagnatrices. Cela est un facteur de fragilisation des cultures.
Les cercles concentriques en périphérie et les amincissements des ramifications en champ médian expriment un problème de stress hydrique (...)
Sur l'image multicentrée 12.72' J1 C0.2 0, (photo n° 5) le phénomène est très marqué, le cloisonnement avec un vide assez conséquent en atteste.
Troisième problème : Acidification
Une tendance à l'acidification est en train de s'installer. Elle se traduit par un aspect rayonnant de la structure et (...). Le phénomène sera plus visible sur les images des plantes accompagnatrices.
Quatrième problème : Evolution de la matière organique
De nombreuses structures transverses sont visibles dans toute la zone intermédiaire : (...). Les structures transverses (...) signifient dans la terre que la matière organique évolue plus vers une putréfaction qu'une décomposition noble. Ces signes sont plus importants à 60 cm de profondeur. On peut voir là une corrélation avec la mauvaise circulation de l'eau et la compaction, qui gênent la transformation de la matière organique que cette matière soit exogène (apports) ou endogène (décomposition des racines..).
La dernière observation notable qui peut être faite tient au fait qu'il y a des dépôts importants sur la périphérie et les terminaisons du champ médian. Cela est encore plus significatif sur les images à concentration faible. Cela peut être des dépôts organiques mais vraisemblablement leur origine serait plus d'ordre inorganique (résidus chimiques), les images des plantes le montrent. Cela constitue pour la terre une source d'intoxication, une sorte "d'empoisonnement" lent et insidieux, préjudiciable tant à la vie du sol qu'aux cultures.
(...) Circulation très difficile de l'eau de manière chronique, dépôts de matière organique à tendance putride et/ou de dépôts inorganiques, manque très important d'oxygène : la terre est "époumonée", obstruée, en train de se scléroser. Le pronostic vital n'est pas encore engagé, mais la terre est en danger.
3°/ Potentialités de fertilité :
Descriptif technique succinct :
Images très riches à faible, voire très faible concentration
Images "racine" avec une riche arborisation et, fait remarquable, pour la plupart une signature "graine", multicentrées (photos n° 5, n° 6, n° 35)
Centre bas
Images "racine" (12.86B" J1 C0.17) ciselées, bien déployées, très fournies - photos n° 3 et n° 32
Grande richesse en arborisation, très dentelée
Beaucoup de finesse de plumetis (12.86B" J1 C0.33) - photo n° 2
Champ inférieur élargi et trouble - Dépôts, qui gagnent une partie du champ médian
Ces dépôts viennent sur champ supérieur (12.86B" J1 C0.33)- photo n° 2
Champ inférieur très élargi (12.72' J1 C0.2 et C0.1) : affaiblissement, épuisement - photos n° 5 et n° 6
Les potentialités de fertilité de la parcelle "La Pièce à Madame" sont sans aucun doute remarquables voire grandioses. L'utilisation de faible concentration pour réaliser les Cristallisations Sensibles dénote une richesse notable en matière azotée (qui pourrait même être excessive).
(...) Les nombreuses signatures "graine" ou même "fruit" (vacuoles du centre germinatif) affirment des aptitudes à la production, à la reproduction. Ces aptitudes sont intrinsèques à cette terre, ancestrales, en quelque sorte génétiques ou biologiques. Le positionnement du centre vers le bas (pour les images unicentrées) ainsi que la richesse des ciselures des images "racine" permettent de dire que ces potentialités sont abouties, épanouies, matures et affirmées.
La grande richesse en arborisation, (...) est à mettre en corrélation avec une richesse en éléments nutritifs subtils type oligo-éléments. Les potentialités de fertilité de cette terre se trouvent enrichies, accrues, "anoblies".
Il faut cependant préciser que ces potentialités sont sous employées en raison des difficultés que rencontre cette terre. Elles sont contenues, retenues, émoussées. Elles sont carrément déclinantes, (...) en passe d'être "brisées". La terre n'arrive pas à exprimer ses potentialités qui s'en trouvent gaspillées.
Elle a pourtant des aptitudes pour produire de la haute qualité qui sont insoupçonnées et étonnantes.
II- Etude des plantes "accompagnatrices"
L'objectif est de vérifier si ces plantes manifestent un état qui reflète celui de la terre. En effet, elles font partie de la flore qui pousse spontanément sur cette parcelle et sont là depuis assez longtemps pour exprimer les qualités mais aussi et surtout les problèmes du sol.Chaque plante a fait l'objet d'un "vieillissement" c'est-à-dire que l'extrait obtenu va servir pour trois cristallisations : une le jour même de la préparation, une 8 jours (J8) après et enfin 16 jours (J16) plus tard. Outre le suivi des effets du sol, ce vieillissement permet aussi de voir la vitalité des plantes.
Images principales : concentration à 0,28 g complétées par des images à faible concentration de 0,10 g avec une concentration faible à très faible de chlorure de cuivre.
Cliquez sur les photos pour les agrandir
- Carotte sauvage - Jour 1
- Carotte sauvage - Jour 1
- Carotte sauvage - Jour 1
- Photo n°7
- Photo n°8
(image complémentaire) - Photo n°9 (image complémentaire)
1°/ Carotte sauvage :
La partie utilisée pour la cristallisation est le feuillage. Une partie de celui-ci est constituée de feuilles matures un peu "roussies".Descriptif technique succinct :
Images principales :
Centre vers le bas
Vacuoles assez profondes, signature "feuille" en J1, peu ou pas lisibles en J8 et J16
Structure plutôt rayonnante en J1 et de plus en plus rayonnante J8 et J16
Dépôts++ en périphérie, taches sur champ médian et champ supérieur et taches (petits points en dessous) en champ médian en J1
Dépôts très prononcés et taches+++ (petits points) en J8
Structure transverse ++ en J16
Etoiles en J16
Elargissement++ champ inférieur sur J1
Amincissement faisceaux en zone intermédiaire = cercle concentrique en J1
(...)
(...)
Cette carotte sauvage est une plante mature en place depuis un certain temps, avec une belle vitalité qui reste visible jusqu'en J16 (images complémentaires).
Elle présente anormalement des signes de dégénérescence (images complémentaires) en J1, puis les signes de vieillissement sont très prononcés dès J8. Cela peut être dû au fait que l'état de la carotte reflète celui du sol ou au fait qu'un agent extérieur (désherbant ?) a accéléré le processus.
Les nombreux dépôts et taches peuvent aussi être liés à une substance inorganique (désherbant ?) ou bien refléter "l'intoxication" du sol.
L'organisation de l'image (photo n° 7) est très semblable de celle de la terre, ce qui montre que la plante se fait le reflet du sol : même feutrage au centre, même disposition en zone intermédiaire, même élargissement de la périphérie. La plante reproduit l'état de la terre.
(...), elle dénote une situation d'acidité, ce qui se rapproche de ce qui se passe pour la terre.
Les striations moirées, très visibles sur les images à faible concentration, sont la manifestation d'un important problème hydrique du sol. Cela est à mettre en parallèle avec la luminosité centrale des images qui rappelle quant à elle les excès de chaleur.
Les images très nettes à faible concentration témoignent d'une richesse en matière azotée, directement liée au sol.
Les observations faites dans l'ouvrage "Les plantes bio-indicatrices" corroborent ce que nous montre la cristallisation sensible : "présence dans les sols à forts contrastes hydriques, plante thermophile".
Il est à noter que la carotte sauvage est une plante "air", lumière. Elle est tout à fait à sa place dans ce sol où elle a une action des plus bénéfiques : aérer, soulever, ameublir, fouiller, atomiser, faire respirer, dilater, régénérer (exsudats de ses racines).
Cliquez sur les photos pour les agrandir
- Chiendent rampant - Jour 1
- Chiendent rampant - Jour 1
- Chiendent rampant - Jour 1
- Photo n°15
- Photo n°16
(image complémentaire) - Photo n°17 (image complémentaire)
2°/ Chiendent rampant :
La partie utilisée pour la cristallisation est le rhizome avec quelques feuilles naissantes (stade du chiendent à cette époque de l'année) en supprimant les racines.Descriptif technique succinct :
Images principales :
Structure plutôt harmonieuse
Rayonnement
Centres germinatifs assez profonds, type "racine" en J1, type plutôt "fruit" en J8, placés vers le bas
Texture riche, dense, bien ramifiée en J1
Feutrage champ supérieur et une partie du champ médian en J1, feutrage champ supérieur et majeure partie du champ médian en J8 et J16
Luminosité accrue en J8 et J15
Structure transverse++ sur deuxième moitié champ médian, en J1
Aiguilles en amas, en "paquets" épais en première partie champ médian en J1
Taches en zone intermédiaire et zone périphérique en J1
Cercles concentriques en périphérie
Amincissement ramifications en champ médian, qui s'est formé par étapes
Striations moirées
Champ inférieur fourni et en partie feutré en J1
Elargissement champ inférieur
(...)
Le chiendent rampant présente beaucoup de similitude avec la carotte sauvage quant à son état. Il exprime une très belle vitalité intrinsèque, mais de nombreux signes montrent qu'il est mis à mal, par un agent extérieur (désherbant ?).
Cette très belle vitalité est représentative des qualités et des potentialités de la terre.
Par ailleurs, il est au diapason du sol manifestant des contrastes hydriques très marqués. (...). Cette alternance s'est inscrite sur une longue période, ce problème est donc déjà installé depuis un certain temps.
Le chiendent traduit également le mouvement plutôt centripète : feutrage central et médian, avec affaiblissement en périphérie. Il se fait l'écho du sol, avec les aiguilles en "paquet", dans ses difficultés de respiration et de circulation des flux. Les images très visibles et très nettes à faible concentration confirment une grande richesse en matières azotées.
La disposition rayonnante à très rayonnante des faisceaux : présence d'acidité qui tend à déséquilibrer le sol dans son fonctionnement et perturbe son comportement.
Là encore, les informations apportées par la cristallisation sensible correspondent aux observations faites dans le livre "Les plantes bio-indicatrices" : "fort contraste hydrique, compactage, excès de nitrate et potasse, déstructuration des sols par les labours".
Le chiendent rampant dont le nom signifie "plante qui élimine l'eau" (drainage) est une plante de nettoyage. Elle a un rôle certes "mécanique" de drainer, d'ameublir, de faire foisonner, de brasser, de travailler avec force mais aussi une action détoxifiante (par absorption ?), également émolliente, exfoliante et astringente sur la texture du sol dans sa partie superficielle. C'est un allié loyal, qui ne représente pas un danger pour le sol ; une réflexion peut-elle être conduite pour le faire "cohabiter" avec les cultures, sachant qu'il disparaîtra ou se réduira fortement lorsque les problèmes seront résolus ?
Cliquez sur les photos pour les agrandir
- Liseron des champs - Jour 1
- Liseron des champs - Jour 1
- Liseron des champs - Jour 1
- Photo n°23
- Photo n°24
(image complémentaire) - Photo n°25 (image complémentaire)
La partie utilisée pour la cristallisation est le rhizome avec quelques bourgeons (stade du liseron à cette époque de l'année) en supprimant les racines.
Descriptif technique succinct :
Images principales :
Image en miroir, J1
Centre très bas
Principe organisateur profond : striations moirées à l'intérieur, J1, signature tendance "feuille" mais peu structurée
Structure très resserrée
Texture dense++, peu ramifiée sur les 2/3 du champ médian
Faisceaux rayonnants
Sites lumineux
Sites importants striations moirées
Rétraction
Dernier tiers médian : texture lâche et pauvre
Elargissement zone périphérique
Dépôts sur une partie de périphérie
Structure transverse en petit nombre
Vieillissement accéléré en J8, très avancé en J16
Luminosité accrue champ supérieur et champ médian en J8 et J16
(...)
L'état du liseron des champs est en cohérence avec celui des deux plantes précédentes. Toujours avec une belle vitalité intrinsèque, le liseron accuse plus que les autres d'une altération : il est malmené, décimé. Encore une fois, cela semble plus le fait de quelque chose qui l'a attaqué (désherbant ?) qu'une évolution normale d'un végétal.
Les images du liseron sont très représentatives, elles aussi, de l'état du sol. Une image est très parlante (J1 C0.1 00 - photo n° 25) en ce qui concerne le problème hydrique. La richesse en azote du milieu est également mise en évidence.
Les informations sont en accord avec ce que nous en dit le livre "Les plantes bio-indicatrices"
Espèce nitratrophile - Saturation CAH par azote organique ou synthèse - Excès MO ou nitrate d'ammonium - Compactage des sols.
Le liseron des champs est lui aussi là pour faire foisonner le sol, comme une grelinette, en profondeur ; il fait un travail remarquable. Il a pour rôle de désengorger, de purger le sol. Comme le chiendent, il assure aussi une action dans la partie superficielle du sol par un aspect exfoliant et astringent ; nettoyant et réparateur.
En synthèse, de façon imagée, ces plantes sont là pour extirper avec force ce qui gêne la terre dans son fonctionnement, la faire "expectorer", faire sortir ce qui l'empêche de respirer.
Conclusion
Il ressort de cette étude que la terre de la parcelle "La Pièce à Madame" a besoin d'aide à trois niveaux :
1 - Besoin urgent et important d'oxygène
2 - Détoxification
3 - Réduire l'acidité
Il conviendrait d'intervenir avec beaucoup d'attention, de tact, (...) en choisissant les moments les plus propices, notamment dans le travail du sol.
Voici des propositions d'actions qui peuvent être entreprises, soit simultanément, soit successivement :
1°/ Travail du sol :
Ce qu'exprime cette terre, c'est la nécessité d'être travaillée énergiquement, d'être scarifiée en profondeur avec l'idée de "tranchant", "d'ouverture". Elle a en effet un besoin impérieux d'être aérée, de respirer (...)
Or, du fait qu'il s'agit d'une terre très argileuse, l'utilisation d'un décompacteur ne serait pas la meilleure réponse tant sur un plan agronomique qu'économique. La mise en place de couverts végétaux avec des plantes au système racinaire puissant semblerait plus adaptée.
2°/ Apports qui peuvent être faits :
Tant pour une action de "nettoyage", de détoxification que pour résorber l'acidification importante, l'utilisation d'un excellent carbonate de calcium d'origine marine serait judicieuse.
Il conviendrait d'en faire des apports fractionnés sur un minimum de trois ans.
Cela serait par ailleurs profitable à la réorientation de la décomposition de la matière organique dans le sol.
Les propositions ne sont bien sûr pas exhaustives. Elles sont une invitation à poursuivre des actions peut être déjà entreprises et à les accompagner par d'autres ou à reconsidérer ce qui est fait actuellement, après cette rencontre en profondeur avec votre terre.
L'agriculteur qui n'avait donné aucune indication lors de l'envoi d'échantillon, m'a précisé après avoir reçu l'étude que lorsqu'il labourait, il se dégageait en plusieurs endroits une odeur de vase. Par ailleurs, il m'a indiqué qu'à l'automne de l'année précédente il avait appliqué du glyphosate dans un dosage très modéré pour "calmer" les adventices. Malgré la faible dose épandue environ six mois auparavant, l'étude des plantes "accompagnatrices" avait permis de déceler la présence probable de désherbant.
Copyrights © 2012-2013 - Tous droits réservés
Site réalisé par Dimz webdesign
Site réalisé par Dimz webdesign